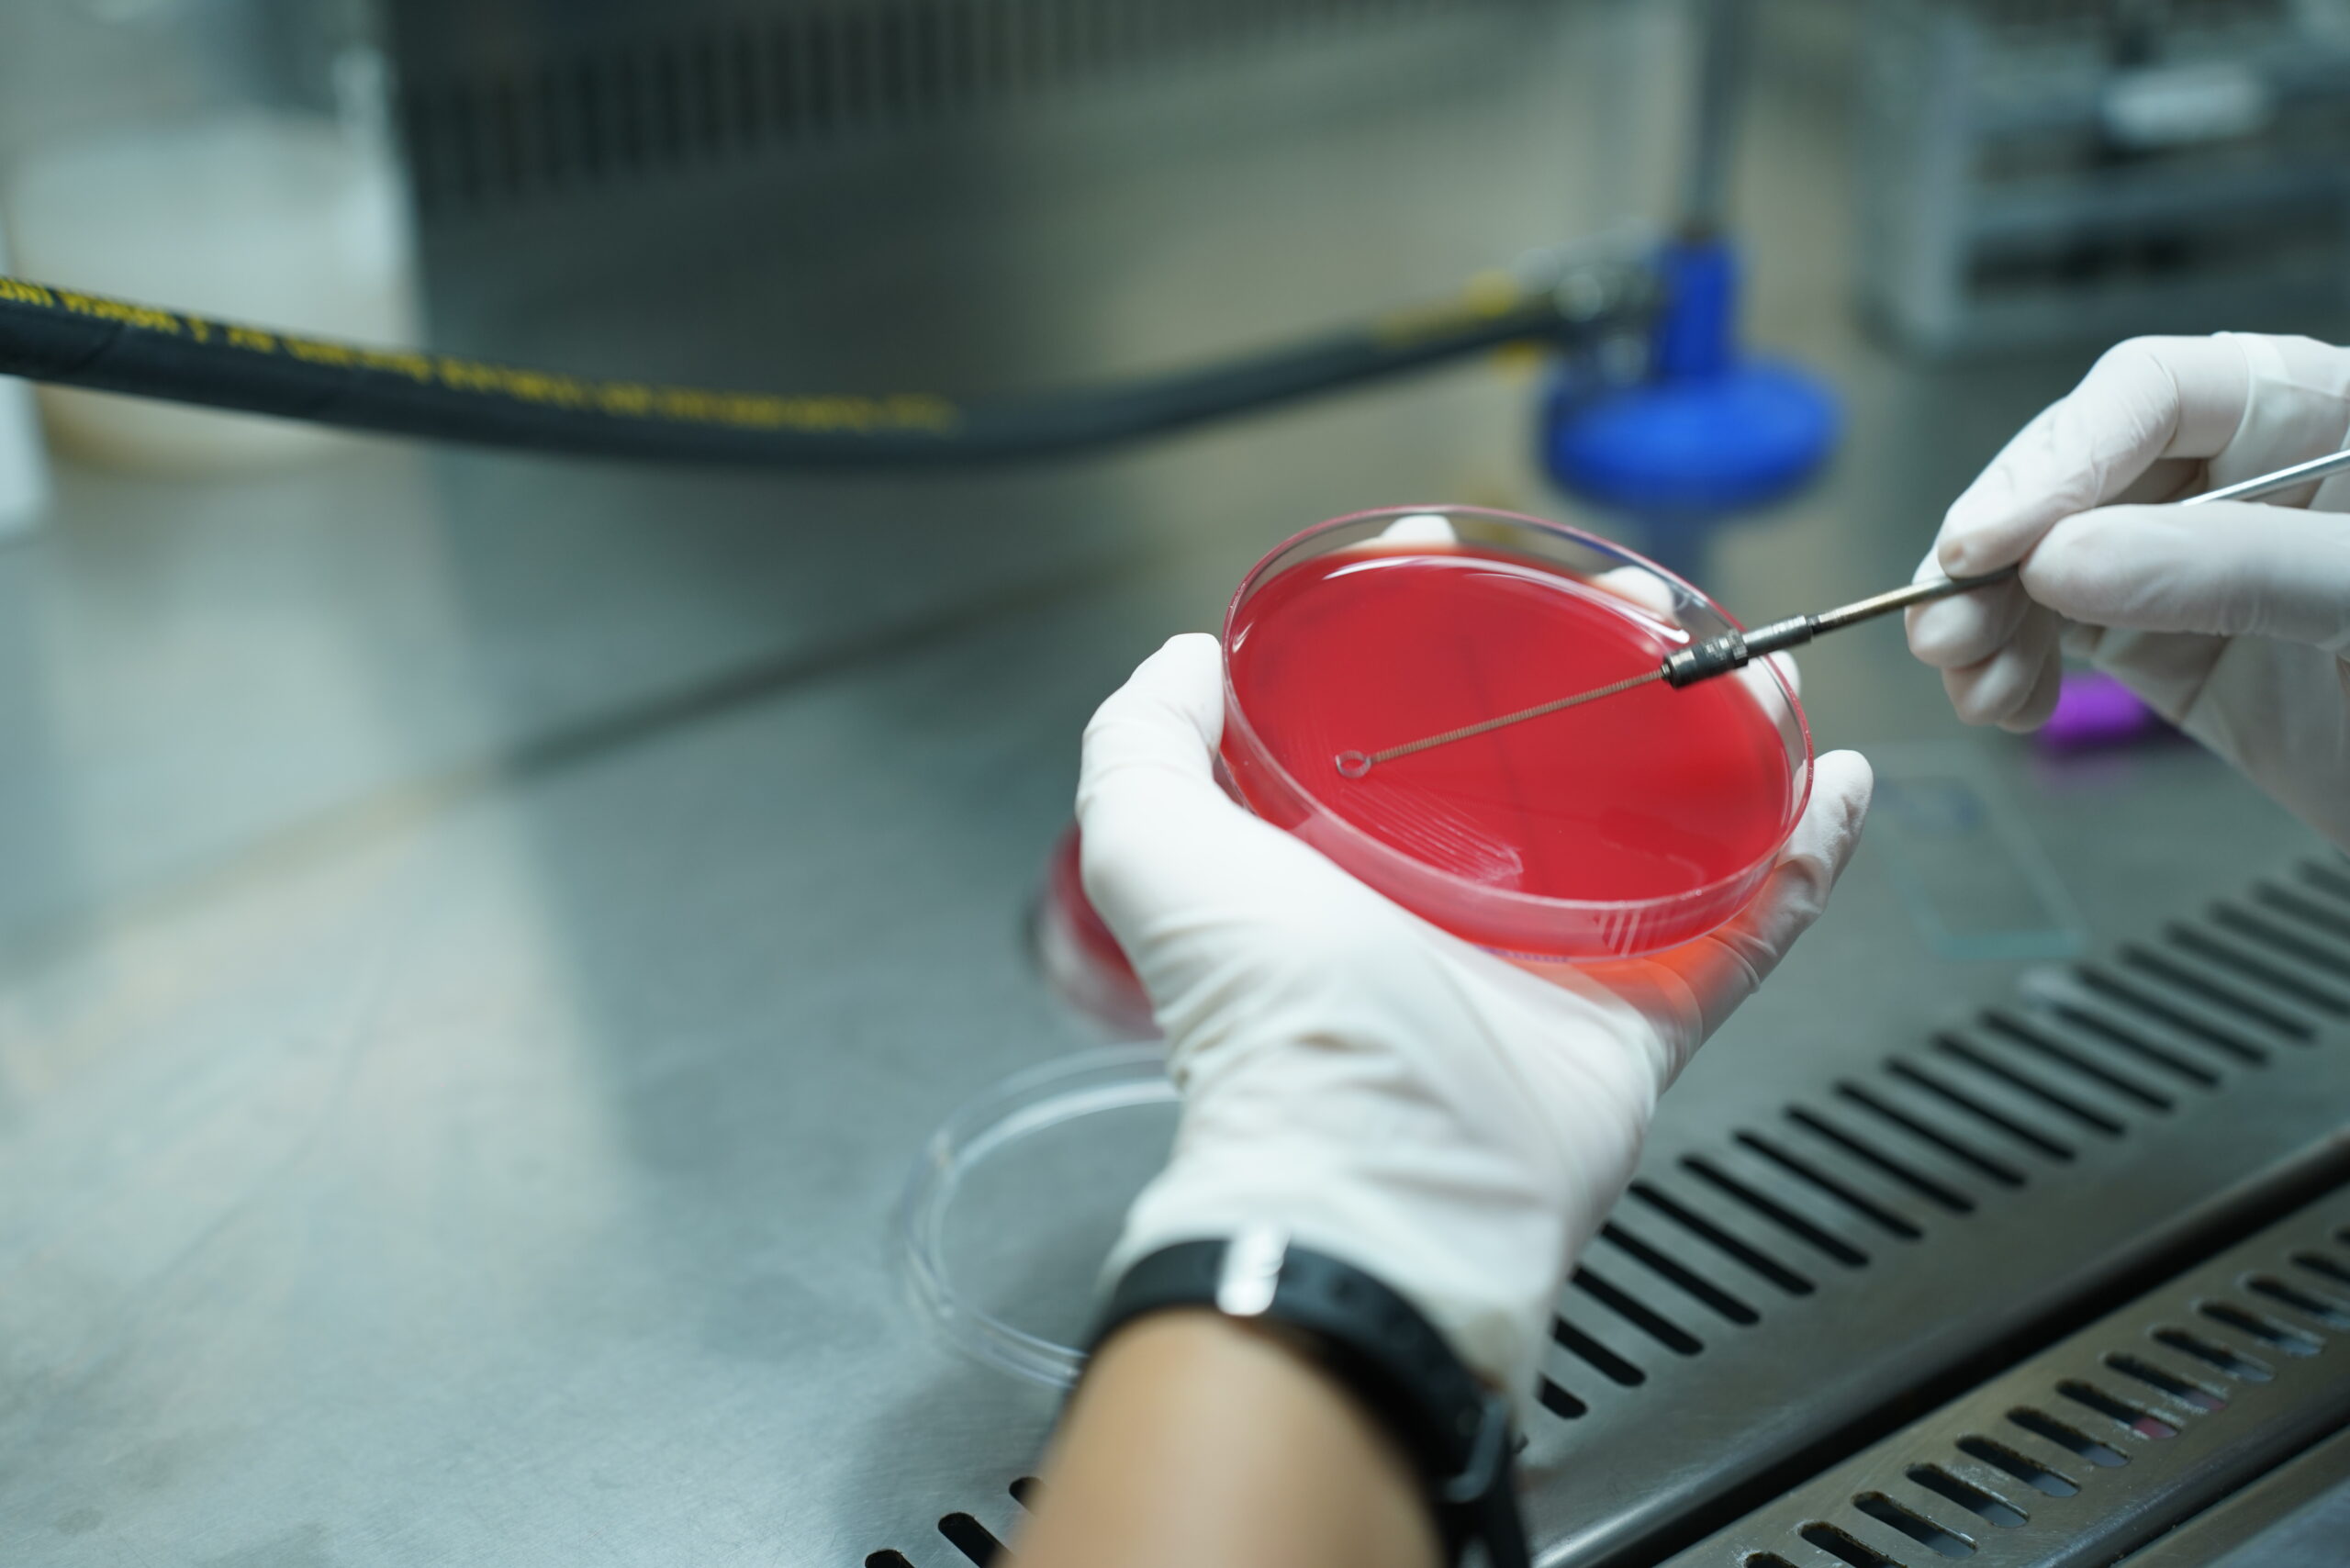

The department of hematology mainly specializes in diagnosis, treatment and management of blood related disorders.
The team comprises of qualified,well trained hematologists who uses
advanced technology to treat blood related disorders like anemia,
leukemia, bleeding disorders and coagulation disorders.
It is a growing Branch of our hospital which deals blood related disorders in both adult and paediatric patients.
Routine bone marrow biopsy and flow cytometry done.
Specialized care for bleeding disorders, clotting abnormalities, and platelet-related conditions.
Early detection, diagnosis, and monitoring of blood cancers and hematological malignancies.
Screening, counseling, and treatment for inherited blood disorders like thalassemia and sickle cell disease.
Regular monitoring and long-term management for chronic hematological conditions.
Treats anemia, blood cancers, bleeding and clotting disorders, thrombosis, and other blood-related conditions.
+91 739 7251 333

Diagnostic tests are used to accurately identify conditions and guide effective treatment planning
CBC helps evaluate overall health by measuring red blood cells, white blood cells, hemoglobin, and platelets.
Peripheral smear study examines blood cells under a microscope to detect infections, anemia, and blood disorders.
PT INR and APTT tests assess blood clotting function and help monitor bleeding or coagulation disorders.
Bone marrow studies help diagnose blood cancers, anemia, infections, and other bone marrow disorders.
Flow cytometry is an advanced test used to identify and analyze abnormal blood cells and immune disorders.





Take the first step toward better health — book your appointment today and experience expert care you can trust.
+91 9345 133 343
Connect with our experienced medical specialists. Get timely, expert care tailored to your health needs.